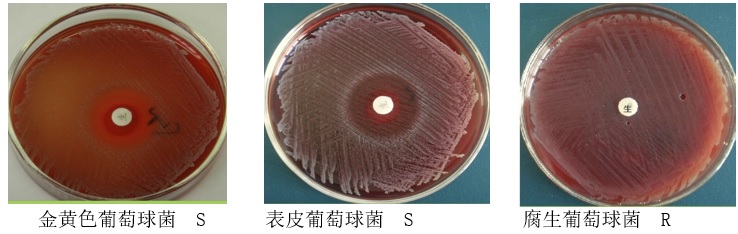
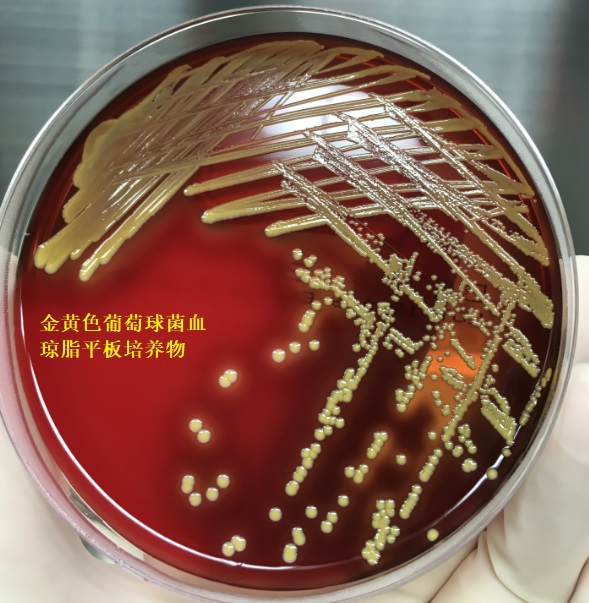
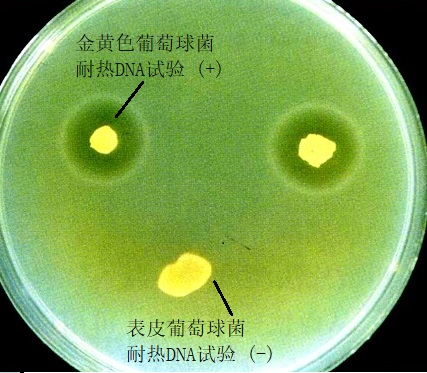
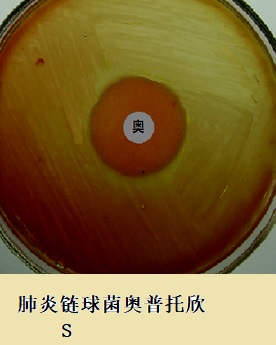
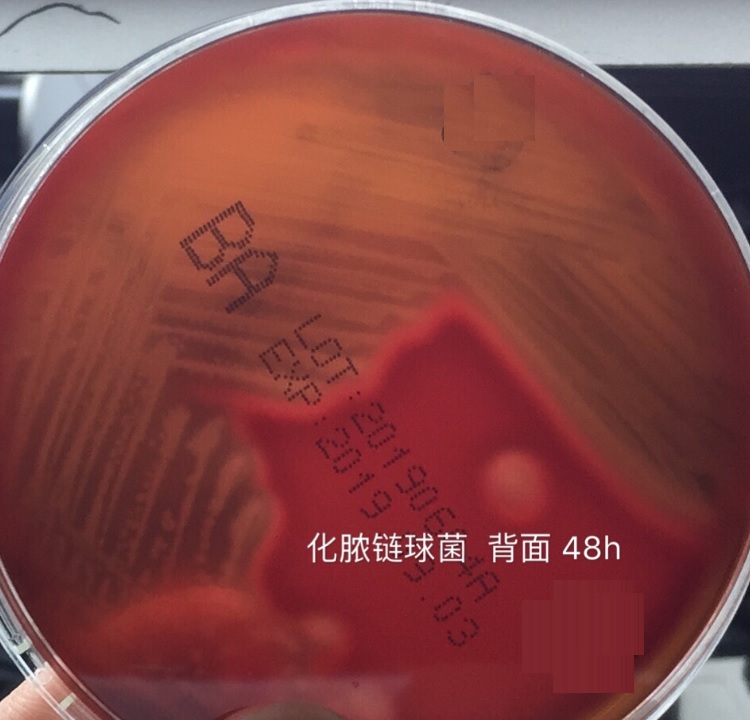
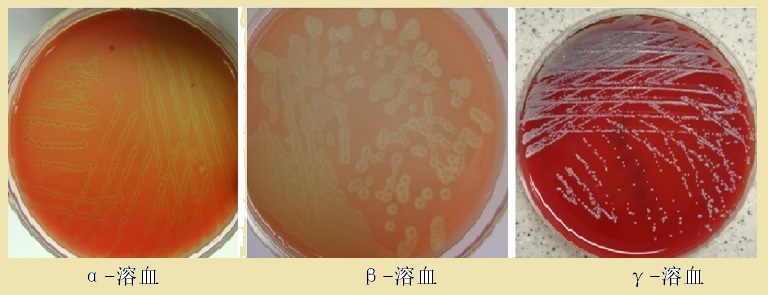
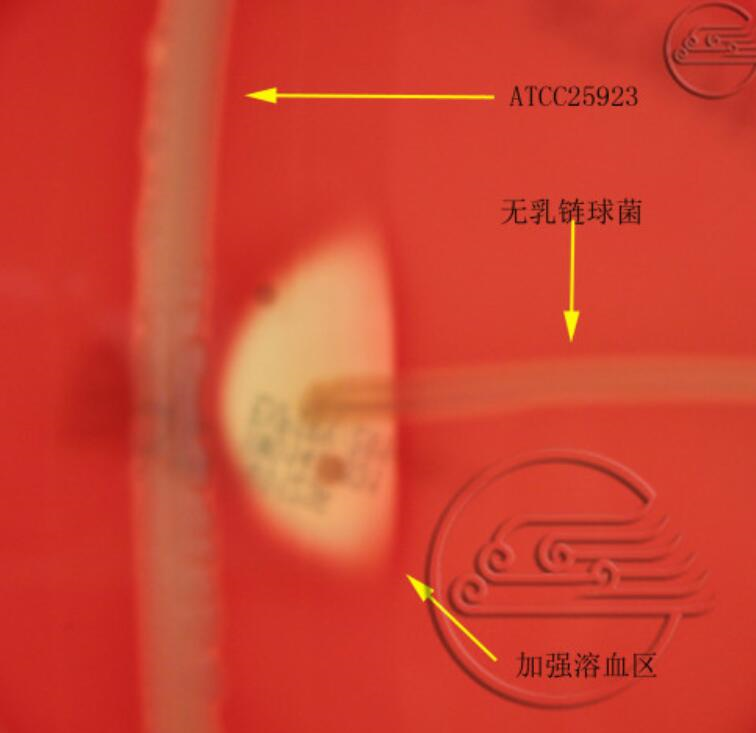

案例1:
病人,张某,女,36岁,因化脓性感染来医院就诊,检验人员采取脓汁标本接种于血琼脂平板,经35℃培养18~24小时,平板上出现中等大小、有β溶血环、光滑、湿润的菌落,取菌落作革兰染色,镜检发现G+球菌,呈葡萄串状排列,触酶试验阳性。该菌可能是什么菌?要鉴定该菌还应做哪些试验?
案例1分析:
疑为金黄色葡萄球菌感染,进一步鉴定应做葡萄糖发酵试验、甘露醇发酵试验、血浆凝固酶试验或金黄色葡萄球菌胶乳凝集试验。
案例2:
一份血液标本,经过2天增菌培养后,在增菌液底层出现沉淀生长现象。将增菌液转种在血琼脂平板上,经培养形成灰白色、圆形、凸起、表面光滑、半透明小菌落,菌落周围形成宽大透亮的溶血环。增菌液直接涂片,革兰染色镜检:G球菌,呈链状排列。该菌可能是什么菌?要鉴定该菌,如何进行进一步的检验?
案例2分析:
疑为链球菌感染,进一步试验应进行触酶试验,如触酶试验阴性,可确认为链球菌属细菌。根据临床上常见的链球菌感染主要是A群溶血性链球菌,应进行杆菌肽药敏试验或应用A群抗血清进行疑集现象进行确诊。
案例3:
患儿,男,10岁,入院前因接触感冒患儿后出现咽痛、轻咳,无流涕、呕吐、腹泻、肌肉酸痛等症状。曾先后应用青霉素、先锋霉素、头孢曲松等抗感染治疗4天,但患儿仍咳嗽,且高热,体温高达39℃以上,患儿咳黄脓痰,痰中带血丝。入院后,住院医生申请微生物室进行细菌培养并做药物敏感试验。你怀疑为何种细菌感染?如何进行检查?
案例3分析:
怀疑为金黄色葡萄球菌感染。检测(略)。
案例4:
某30岁男性病人,有尿频、尿急、尿痛等症状,并且尿道口有脓性分泌物,脓性分泌物涂片革兰染色镜检发现大量白细胞,在白细胞内发现革兰阴性双球菌,此病人最有可能感染何种病原体?此类标本的送检有何注意事项?
案例4分析:
此病人最有可能感染淋病奈瑟菌,俗称“淋球菌”,急性感染细菌位于白细胞内,且为革兰阴性双球菌。对于怀疑感染淋球菌的标本需及时并保温送检。
金黄色葡萄球菌是葡萄球菌属中最常见的致病菌。临床上主要依据镜下形态学特征、培养特征,以及血浆凝固酶试验、甘露醇发酵、触酶试验等加以鉴定。
链球菌属种类多,形态与培养特征与葡萄球菌属相似,两者可借触酶试验进行鉴别。链球菌属营养要求高,分离培养常用血液琼脂平板。根据链球菌在血琼脂平板上的溶血现象可分为甲型溶血性链球菌、乙型溶血性链球菌和丙型链球菌;根据链球菌多糖抗原可将其分为A、B、C等群。杆菌肽试验、CAMP试验、BGUR试验分别有助于A、B、C群链球菌的鉴定;胆盐溶菌试验、菊糖发酵试验、Optochin敏感试验有助于肺炎链球菌和甲型链球菌的鉴别。
肠球菌属是医院感染的重要致病菌,实验室鉴定主要依据触酶试验、PYR试验、胆汁七叶苷试验和6.5%NaCl耐盐试验等生化试验。
奈瑟菌属主要致病菌有脑膜炎奈瑟菌和淋病奈瑟菌,临床常通过染色镜检,以及氧化酶糖类发酵和血清学试验等方法进行鉴定,麦芽糖分解和30%触酶试验可鉴别此两种菌。奈瑟菌属对外界抵抗力弱,尤其对寒冷、干燥和热更为敏感,因此在采集和运送标本时需保温、保湿送检,培养基预温,最好床边接种。